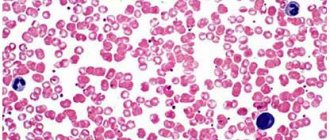

Тромбоцитопения у детей и взрослых может быть самостоятельной болезнью (первичная форма) или симптомом патологий других систем и органов (вторичная тромбоцитопения). Наиболее часто проблема встречается у дошкольников и людей старше 40 лет.
По критерию продолжительности протекания в организме заболевание классифицируют на:
- Острое. Мгновенной симптоматики нет, тромбоцитопения воздействует на органы не более шести месяцев.
- Хроническое. Снижение тромбоцитов в крови продолжается более полугода. Лечение длительное, занимает до двух лет.
Причины
Тромбоциты представляют собой форменные элементы крови, безъядерные плоские пластинки размером от 1 до 2 мкм. Они образуются из мегакариоцитов (клеток-предшественников) в красном костном мозге.
Мегакариоциты — относительно большие клетки. Они имеют длинные отростки и почти полностью заполнены цитоплазмой. В ходе созревания крошечные фрагменты их отростков отделаются и поступают в кровоток. Это и есть тромбоциты. Согласно научным данным, из одной клетки-донора может образоваться от 2000 до 8000 тромбоцитов.
За развитие и рост мегакариоцитов отвечает тромбопоэтин — белковый гормон, образующийся в почках, печени и мышцах. С кровотоком он переносится в красный костный мозг, где обеспечивает образование мегакариоцитов и тромбоцитов. Чем больше становится тромбоцитов, тем сильнее тормозится процесс образования тромбопоэтина. Это позволяет поддерживать количество форменных элементов крови на одном уровне.
Если на любом из перечисленных этапов происходит сбой, количество тромбоцитов в периферической крови снижается. Развивается тромбоцитопения.
С учетом причин и механизма развития заболевание бывает разных форм:
- наследственная;
- продуктивная;
- разрушения;
- потребления;
- перераспределения;
- разведения.
Наследственные тромбоцитопении
Наследственная тромбоцитопения наблюдается при разных врожденных аномалиях. Ее причины — генетические мутации:
- Синдром Вискотта-Олдрича. Вызван мутациями, из-за которых в красном косном мозге образуются очень маленькие тромбоциты (менее 1 мкм в диаметре). Из-за аномальной структуры они быстро (за несколько часов) разрушаются в селезенке.
- Аномалия Мея-Хегглина. Очень редкая генетическая патология, по причине которой нарушается процесс отделения тромбоцитов от мегакариоцитов. Как результат, уменьшается число форменных элементов крови, но их размеры становятся гигантскими (6-7 мкм). Параллельно наблюдается нарушение образования лейкоцитов (лейкопения).
- Врожденная амегакариоцитарная тромбоцитопения. Обычно данная форма тромбоцитопении диагностируется у детей младенческого возраста. Она связана с нарушением продукции тромбоцитов костным мозгом.
- Синдром Бернара-Сулье. Тромбоцитопения у ребенка проявляется лишь, если он унаследовал дефектный ген и от мамы, и от папы. Болезнь заявляет о себе в раннем детском возрасте. Для нее характерно образование функционально несостоятельных гигантских тромбоцитов (6-8 мкм), не способных прикрепляться к поврежденным сосудистым стенкам и связываться друг с другом.
- TAR-синдром. Очень редкая причина врожденной тромбоцитопении, сочетающейся с отсутствием обеих лучевых костей.
Продуктивные тромбоцитопении
К группе продуктивных тромбоцитопений относятся патологии системы кроветворения, связанные с нарушением процесса образования тромбоцитов в красном костном мозге. Причины заболеваний:
- Острый лейкоз. Стволовые клетки мутируют, появляется большое количество их клонов, не способных выполнять специфические функции. Постепенно клоны вытесняют кроветворные из красного костного мозга. Уменьшается не только число тромбоцитов, но и количество лейкоцитов, лимфоцитов и эритроцитов.
- Миелодиспластический синдром. Костный мозг не может продуцировать достаточное количество здоровых клеток. Клетки кроветворения ускоренно размножаются, однако процессы их созревания нарушаются. В итоге образуется много функционально незрелых клеток (среди них тромбоциты), подвергающихся апоптозу (саморазрушению).
- Апластическая анемия (организм вырабатывает очень мало новых кровяных телец).
- Раковые метастазы. Опухолевые клетки на последних стадиях рака начинают покидать первичный очаг и разноситься по всему организму. Оседая на тканях и органах, они начинают активно размножаться. Это приводит к вытеснению кроветворных клеток из красного костного мозга.
- Миелофиброз. Стволовые клетки мутируют, костный мозг заменяется рубцовой тканью. Очаги кроветворения развиваются в печени и селезенке (размеры органов из-за этого сильно увеличиваются).
- Радиация. Ионизирующее излучение оказывает разрушающее действие на кроветворящие клетки красного костного мозга. Они начинают мутировать.
- Алкоголизм. Спирт угнетает процессы кроветворения в красном костном мозге, из-за чего снижается содержание в крови тромбоцитов, лейкоцитов и эритроцитов.
- Цитостатические медикаменты. Применяются для лечения опухолей. Они способны угнетать кроветворение в костном мозге, из-за чего уменьшается количество тромбоцитов.
- Аллергические реакции на определенные медицинские препараты (диуретики, антибиотики, антипсихотики, противосудорожные и противовоспалительные препараты, противодиабетические средства).
- Мегалобластные анемии. Развиваются при дефиците фолиевой кислоты и витамина В12.
Тромбоцитопения разрушения
Причина тромбоцитопении в данном случае — усиленное разрушение тромбоцитов в селезенке (может быть также в лимфатических узлах, сосудистом русле или печени). Патология наблюдается при:
- тромбоцитопении новорожденных;
- синдроме Эванса-Фишера;
- некоторых вирусных заболеваниях (вирусные тромбоцитопении);
- посттрансфузионной тромбоцитопении;
- приеме медикаментов (лекарственные тромбоцитопении);
- идиопатической тромбоцитопенической пурпуре.
Тромбоцитопения новорожденных
Возникает, если на поверхности детских тромбоцитов есть антигены, которых нет на материнских тромбоцитах. Антитела, вырабатываемые материнским организмом, поступают в кровоток новорожденного и разрушают его тромбоциты. Описанный процесс может длиться до 20 недели внутриутробного развития. В итоге ребенок может родиться с тромбоцитопенией.
Синдром Эванса-Фишера
Является следствием системных заболеваний — аутоиммунного гепатита, ревматоидного артрита, системной красной волчанки. Также синдром Эванса-Фишера может развиться на фоне относительного благополучия. Тогда говорят об идиопатической тромбоципении.
Вирусные тромбоципении
Попадая в организм, вирусы активно размножаются. На поверхности пораженных клеток образуются антитела, также изменяются собственные клеточные антигены. Пораженные клетки разрушаются в селезенке. Среди вирусов, способных вызвать тромбоципению — корь, краснуха, грипп, ветрянка.
Посттрансфузионная тромбоцитопения
Посттрансфузионные тромбоцитопении являются следствием переливания тромбоцитарной массы или крови. Для них характерно выраженное разрушение тромбоцитов в селезенке. Причина заболеваний состоит в попадании в организм во время переливания чужеродных тромбоцитов, к которым и начинают вырабатываться антитела.
Лекарственная тромбоцитопения
Некоторые лекарства могут связываться на поверхности кровяных клеток с антигенами. К образовавшимся комплексам вырабатываются антитела, из-за чего тромбоциты начинают разрушаться в селезенке. Среди «провоцирующих» препаратов — «Хинидин», «Мепробамат», «Хлорохин», «Ранитидин», «Гепарин», «Циметидин», «Гентамицин», «Ампициллин» и др.
Идиопатическая тромбоцитопеническая пурпура
Идиопатическая тромбоцитопеническая пурпура (она же аутоиммунная тромбоцитопения или эссенциальная тромбоцитопения) характеризуется резким снижением уровня тромбоцитов в периферической крови. При этом состав других кровяных элементов не нарушается.
Идиопатическая тромбоцитопеническая пурпура: от Верльгофа до наших дней
Спонтанное кожное кровотечение, известное более 2500 лет, уже тогда, в греческом и римском периоде врачевания, называлось «пурпурой». В 1735 году Паул Верльгоф (ИТП называют также «болезнью Верльгофа») описал 16-летнюю девочку с носовым кровотечением и кровотечением слизистых, которые купировались применением лимонной кислоты. Он назвал это заболевание «Morbus Maculosus Haemorhhagicus». Но заметного прогресса в лечении больных с ИТП достигли позже: в 1916 году в Праге профессор Шлоффер удалил селезенку у женщины с этим заболеванием. После операции последовало значительное увеличение числа тромбоцитов. И до сих пор спленэктомия является одним из вариантов лечения пациентов при ИТП. Однако наиболее полная картина этой патологии, наше представление о механизмах ее возникновения и подходах к диагностике и терапии начали складываться лишь в последнее время.
Идиопатическая тромбоцитопеническая пурпура (ИТП), или первичная иммунная тромбоцитопения (ИТП), является аутоиммунным приобретенным заболеванием, которое характеризуется изолированной тромбоцитопенией числом тромбоцитов ниже 100х109/л. Оно может проявляться геморрагическим симптомом различной степени выраженности – от петехиальных кожных кровоизлияний до угрожающих жизни кровотечений. Болеют и дети, и взрослые. Этиология ИТП неизвестна. Поэтому и называется «идиопатическая». Среди пусковых факторов наибольшую группу составляют инфекции, беременность, а также прививки, стрессы.
Известно, что доминирующий механизм развития тромбоцитопении при ИТП обусловлен выработкой аутоантител к структурам мембраны тромбоцитов и их предшественников – мегакариоцитов, которые приводят к повышенному разрушению тромбоцитов фагоцитами, главным образом в селезенке, реже в печени, и недостаточной выработкой тромбоцитов в костном мозге. У пациентов с ИТП вырабатываются главным образом IgG аутоантитела против гликопротеинов GPIIb/IIIa или GPIb/IX поверхности тромбоцитов. Процесс формирования иммунной реакции на собственные тромбоциты – сложный, многоступенчатый, циклический. В нем принимают участие В-лимфоциты, Т-лимфоциты, NK-клетки, макрофаги. Помимо антителообразования, большую роль в патогенезе ИТП играют субпопуляции Т-лимфоцитов, развитие дисбаланса Т-клеточного звена иммунного ответа. Выявлена связь между ИТП и некоторыми генами-кандидатами, что указывает и на наличие генетической предрасположенности к ИТП.
С учетом сопутствующей патологии у пациента образуется определенный фенотип заболевания. Таким образом, патогенез ИТП связан с глубокими нарушениями иммунной системы. В связи с этим идиопатическая тромбоцитопеническая пурпура переименована на первичную иммунную тромбоцитопению с неизвестной этиологией. Соответственно, при всех других формах иммунная тромбоцитопения с известной этиологией будет симптомом других аутоиммунных заболеваний – системной красной волчанки (СКВ), антифосфолипидного синдрома (АФЛС), ревматоидного артрита (РА) и др.
В настоящее время продолжается поиск этиопатогенетических механизмов развития этой редкой патологии, которые могли бы стратифицировать пациентов на группы риска для индивидуализации лечебной тактики.
В литературе ИТП описывается как редкое, орфанное, заболевание. Надо сказать, что в медицинском мире не существует единого определения этой группы заболеваний. В одних странах орфанные патологии выделяют в зависимости от количества страдающих, в других – от доступности методов лечения, в третьих – к редким заболеваниям относят только хронические, угрожающие жизни.
В России своя история орфанных заболеваний. С того времени, как в нашей стране законодательно было принято определение «орфанные заболевания» (закон № 323 «Об основах охраны здоровья граждан в РФ» от 21.11.2011)1, а именно: редкими (орфанными) заболеваниями являются заболевания, которые имеют распространенность не более 10 случаев заболевания на 100 тысяч населения, все онкогематологические и многие гематологические заболевания стали считаться орфанными. Что касается ИТП, согласно Постановлению Правительства РФ № 403 от 26.04.20122 идиопатическая тромбоцитопеническая пурпура (D69.3) была включена в короткий список жизнеугрожающих и хронических прогрессирующих редких (орфанных) заболеваний, приводящих к сокращению продолжительности жизни граждан или их инвалидизации. В этот короткий список были включены и такие гематологические состояния, как пароксизмальная ночная гемоглобинурия (болезнь Маркиафавы-Микели), апластическая анемия, наследственные болезни нарушения метаболизма, гемолитико-уремический синдром и др.
Все эти законодательные решения привели к тому, что в ФГБУ «НМИЦ гематологии» в 2012 году было создано отделение – стационар орфанных заболеваний (руководитель: профессор Е.А. Лукина). Нозологический диапазон патологий, которыми занимается отделение, очень широк.
Лекарства, разработанные для лечения редких заболеваний, также называются орфанными препаратами и включены список дорогостоящих ЛС. Назначение орфанного статуса заболеваниям и любым лекарственным препаратам – социальный, политический вопрос во многих странах, как и в России. Поддержка исследований редких болезней со стороны правительств привела к прорывам в медицине, которые не могли бы быть достигнуты в рамках до этого существующей системы финансирования.
Статус орфанного заболевания для ИТП также открывал новые возможности для улучшения его диагностики и лечения современными методами, которые не могли бы быть осуществлены без него. Речь идет прежде всего о двух орфанных дорогостоящих препаратах агонистов тромбопоэтиновых рецепторов (аТПО) (ромиплостим от «Новартис» и элтромбопаг от «Амджен»). Лекарственное обеспечение осуществляется за счет бюджетов субъектов Российской Федерации.
Эпидемиология
Надо напомнить, что в нашей стране на популяционном уровне заболеваемость ИТП до 2014 года не была изучена. И информации для оценки особенности течения, эффективности и безопасности различных вариантов терапии больных ИТП было недостаточно. Для решения этих проблем под эгидой Национального гематологического общества (председатель Наблюдательного совета НГО – главный внештатный гематолог РФ, директор ФГБУ «НМИЦ гематологии» Минздрава России, академик РАН, профессор В.Г. Савченко) в начале декабря 2012 года был сформирован и начал функционировать «Регистр заболеваний системы крови».3 С 2014 года стартовала работа и в его подразделе «ИТП» – началось многоцентровое проспективное наблюдательное когортное исследование «Эпидемиологические и клинические характеристики ИТП у взрослых в России» (руководитель: А.Л. Меликян).
Согласно данным регистра Национального гематологического общества (НГО), заболеваемость взрослого населения ИТП в РФ среднем составляет 2,0 (1,6‒3,6) на 100 тысяч населения в год. ИТП не имеет географических особенностей. Мужчины болеют в 2‒3 раза реже женщин. Наибольшая доля пациентов (45,4%) находилась в возрастной группе от 18 до 40 лет, в группе от 41 до 60 лет – 26,0% и старше 60 лет – 28,6%. Таким образом, среди пациентов с ИТП 71,4% находятся в трудоспособном возрасте. Наибольшая частота встречаемости ИТП была зарегистрирована у женщин в фертильном возрасте 4. Полученные нами результаты вполне сопоставимы с данными регистров других европейских стран.
Диагностика
Главным клиническим проявлением ИТП является геморрагический синдром, и прогноз течения заболевания всецело зависит от степени его тяжести. Риск развития кровотечений у больных с ИТП оценивается по количеству тромбоцитов в анализе периферической крови. Согласно данным регистра, в 70,0% случаев количество тромбоцитов в дебюте заболевания составляет от 3 до 30х109/л, среди них у 35% выявляется критический уровень тромбоцитов (от 3 до 10х109/л) с риском развития спонтанных настораживающих, жизнеугрожающих кровотечений, что требует незамедлительного назначения лечения.
Геморрагический синдром проявляется в виде: кожных геморрагий – 77% случаев; кровоточивости слизистых полости рта – 39%; носового кровотечения – 31%; менометроррагии – 15% (среди женщин); желудочно-кишечного кровотечения – 7%; гематурии – 4%; внутримозгового кровотечения – 0,9%, других – 1% (кровоизлияния в сетчатку глаз, геморроидального кровотечения).4
Таким образом, около 1/3 пациентов на момент постановки диагноза имеют геморрагические проявления, соответствующие тяжелой форме ИТП (3‒4-й степени кровоточивости по классификации ВОЗ). ИТП – заболевание не генетическое, но обычно сопровождает пациента на протяжении всей его жизни и является неизлечимым. Течение заболевания осложняется еще тем, что у 60‒70% пациентов через 12 месяцев (хроническая фаза) заболевание приобретает хронический, рецидивирующий характер, вновь.
ИТП – заболевание не генетическое, но обычно сопровождает пациента на протяжении всей его жизни и является неизлечимым. Течение заболевания осложняется еще тем, что у 60‒70% пациентов через 12 месяцев (хроническая фаза) заболевание приобретает хронический, рецидивирующий характер, вновь появляется геморрагический синдром, требующий проведения противорецидивного курса терапии.
Диагноз «ИТП» – это диагноз исключения, т.е. до настоящего времени нет ни одного специфического теста заболевания. Тромбоцитопении различного генеза регистрируются при широком спектре заболеваний гематологической, негематологической и врожденной природы, у которых длительное время доминирующим клиническим симптомом может быть изолированная тромбоцитопения. Поэтому для установления истинных причин тромбоцитопении необходимо проведение расширенного диагностического поиска в дебюте заболевания.4
Первоначальный подход к диагностике причин тромбоцитопении основывается на анамнезе пациента (его фоновых заболеваниях и предшествующей медикаментозной терапии), его объективном физическом осмотре и обследовании по протоколу. Разработанный нами протокол дифференциального диагноза тромбоцитопений включен в Национальные клинические рекомендации по ИТП.5 Самое главное, что все предложенные лабораторные и инструментальные исследования существуют в рутинной практике и их проведение обязательно для всех пациентов с подозрением на ИТП.
После исключения других причин тромбоцитопении диагноз ИТП устанавливается на основании следующих критериев:
- изолированная тромбоцитопения менее 100,0х109/л, зарегистрированная минимум в двух последовательных анализах крови;
- отсутствие морфологических и функциональных аномалий тромбоцитов;
- отсутствие патологии лимфоцитов, гранулоцитов и эритроцитов;
- нормальные показатели гемоглобина, эритроцитов и ретикулоцитов, если не было существенной кровопотери;
- повышенное или нормальное количество мегакариоцитов в миелограмме;
- нормальные размеры селезенки.
Важно иметь в виду: нередко для быстрого купирования геморрагического синдрома пациентам без обследования по протоколу назначаются кортикостероиды, что смазывает истинную клиническую картину вторичных иммунных тромбоцитопений и влияет на истинные результаты иммунологических анализов. По данным нашего отделения, до 15‒20% случаев в динамике при повторном обследовании по протоколу диагноз ИТП заменяется на другой. Картина болезни может меняться с течением времени, в связи с этим необходимо постоянно обновлять данные о состоянии больного, дифференциальную диагностику проводить на каждом этапе наблюдения/терапии ИТП. Таким образом, очень важно дифференциальный диагноз проводить между первичной и вторичной тромбоцитопенией не только в дебюте заболевания, но и при рецидиве тромбоцитопении.
Установление истинных причин тромбоцитопении крайне важно для выбора адекватной терапии таких пациентов
Во многих случаях пациенты с первичной и вторичной ИТП получают аналогичное лечение. Тем не менее, если ИТП развивается на фоне основного заболевания (например, СКВ, АФС, HCV-инфекции, ВИЧ-инфекции или лимфопролиферативного заболевания), то лечение должно быть направлено главным образом на него.
Следует отметить, что осведомленность наших врачей об этом заболевании находится на достаточно высоком уровне. Во-первых, как выше сказано, ИТП описано 275 лет тому назад. Во-вторых, ИТП ‒ довольно распространенное среди редких заболевание. Ежегодно только в нашем отделении консультируются более 300 пациентов с диагнозом ИТП или с подозрением на нее. И наконец, впервые в России (в 2014 г.) разработаны Национальные клинические рекомендации (НКР) по диагностике и лечению идиопатической тромбоцитопенической пурпуры у взрослых наряду с другими нозологиями по инициативе Минздрава России.4 Данные рекомендации постоянно обновляются и общедоступны.4 Последняя редакция опубликована в 2021 году.
В 2021 году вышли обновленные клинические рекомендации Американской ассоциации гематологов (ASH) и обновленный Международный консенсус по диагностике и лечению первичной иммунной тромбоцитопении. Мы анализировали данные рекомендации и сравнивали с российскими клиническими рекомендациями по ИТП.
Хочу сказать, что глобальных изменений мы не заметили: особое внимание уделено правильной диагностике, а также более детально описаны подходы к лечению.
Кроме того, изучение ИТП входит в учебные и научные планы нашего Гематологического центра для гематологов, ординаторов, слушателей на циклах повышения квалификации ФГБУ «НМИЦ гематологии» Минздрава России и для специалистов других специальностей, поскольку имеются гематологические маски разных заболеваний. Наш Центр организует для врачей-специалистов стажировки на рабочем месте по актуальным вопросам гематологии как для гематологов, так и других специалистов. Все эти программы включены в систему непрерывного медицинского образования. В эру цифровизации и дистанционных образовательных технологий, проведения вебинаров, мастер-классов, обсуждения конкретных клинических примеров значительно расширяется аудитория обучающихся, что способствует непрерывному профессиональному росту врачей.
Лечение
Спленэктомия (СЭ), введенная в практику лечения еще в начале прошлого века Шлоффером, и сегодня является одним из вариантов лечения пациентов при ИТП. Она выполняется относительно часто, но в течение последних трех лет число таких вмешательств снизилась с 26 до 17%, при этом доля пациентов, получающих современные ЛС (агонисты тромбопоэтиновых рецепторов, аТПО) увеличилась с 5,9 до 45,7%. Такая же тенденция наблюдается и за рубежом, где частота выполнения спленэктомии меньше, чем в РФ.
С 1951 года в терапии заболевания используются кортикостероиды, до сих пор они остаются первой линией терапии пациентов с впервые диагностированной ИТП в зарубежных и российских протоколах – при геморрагическом синдроме и тромбоцитах менее 30‒50,0х109/л или при отсутствии геморрагического синдрома при тромбоцитопении 9/л.
Согласно данным нашего регистра, в 92,2% случаев в качестве первой линии пациенты получают лечение кортикостероидами как в виде стандартного лечения, так и пульс-терапии с эффективностью до 70‒80% с быстрым купированием геморрагического синдрома и повышением количества тромбоцитов выше безопасного уровня. Однако после отмены препарата быстро наступает рецидив заболевания. Кортикостероиды – эффективные средства, но с ними связано большое число потенциальных осложнений: сахарный диабет; тяжелые формы артериальной гипертензии и аритмий; язвенная болезнь ЖКТ, активные инфекции; психические расстройства. Поэтому повторные и частые курсы нежелательны. Во всех клинических рекомендациях строго ограничена продолжительность лечения кортикостероидами до 3‒4 недель. К сожалению, из-за доступности кортикостероиды назначаются и на последующих линиях терапии.
В 1980 году в университете при детской больнице в Берне 12-летнего мальчика с острой ИТП и иммунодефицитом лечили внутривенным иммуноглобулином (ВВИГ), что привело к заметному увеличению числа тромбоцитов в течение 24 часов. С тех пор ВВИГ широко и успешно применяется как в первой, так и в последующих линиях терапии в качестве «скорой помощи» в экстренных и жизнеугрожающих ситуациях и является совершенно неоценимым средством для лечения беременных с ИТП. ВВИГ в качестве первой линии терапии эффективен в 80% случаев, гемостатический эффект наступает на 1‒2-й день, длительность ответа – 1‒4 недели. Таким образом, фактически после первой линии терапии почти все пациенты – кандидаты второй линии терапии.
Для систематизации порядка назначения вариантов терапии международной рабочей группой по изучению ИТП выделены 3 стадии заболевания:
- впервые диагностированная с длительностью до 3 месяцев от момента диагностики;
- персистирующая с длительностью 3‒12 месяцев;
- хроническая с длительностью более 12 месяцев.
А последовательность назначения терапии при ИТП, разработанной на основании многолетнего клинического опыта, получила название линий терапии, которые в основном соответствуют стадиям заболевания.
В конце 2000 года, без сомнения, начинается новая эра лечения ИТП: препаратами современного поколения – стимуляторами тромбоцитопоэза, агонистами тромбопоэтиновых рецепторов, аТПО – ромиплостимом («Новартис») и элтромбопагом («Амджен»). В 2009 году они были одобрены в России как орфанные препараты для взрослых с рефрактерной хронической ИТП с/без спленэктомии. В 2015 году оба препарата включили в Перечень жизненно необходимых и важнейших лекарственных препаратов для медицинского применения, утверждаемый распоряжением Правительства Российской Федерации. Использование аТПО (эти данные основаны на доказательной медицине и подкреплены несколькими основательными и очень качественными проспективными контрольными исследованиями) эффективно как до спленэктомии, так и после нее. С появлением данных препаратов прогноз заболевания улучшился, так как они предотвращают развитие тяжелых побочных эффектов лечения и позволяют добиться 80%-ного уровня непосредственного эффекта.1,6
Я считаю (как и многие мои коллеги) их важными особенностями – органосохраняющий и кортикостероидсдерживающий эффекты.
В клинической практике сравнительно недавно появился еще один препарат для лечения ИТП – ритуксимаб, который разработан для лечения гематологических злокачественных заболеваний. В настоящее время ритуксимаб используется для лечения пациентов с ИТП, устойчивых к другим методам лечения. Его использование при хронической ИТП основывается на удалении аутореактивных В-лимфоцитов. Ритуксимаб включен в качестве 3-й линии терапии. Отмечается примерно 60%-ная вероятность получить первичный ответ. Но в России он не зарегистрирован для лечения ИТП, поэтому решение принимается индивидуально врачебной комиссией.
В 2021 году Управление по контролю качества пищевых продуктов и лекарственных средств США (FDA) одобрило новый пероральный лекарственный препарат – селективный низкомолекулярный ингибитор селезеночной тирозинкиназы, фостаматиниб – для медицинского применения у пациентов с резистентной ИТП. А в 2021 – биодоступный агонист малой молекулы рецептора тромбопоэтина, аватромбопаг – для лечения взрослых пациентов с хронической ИТП, которые имели недостаточный ответ на предыдущую терапию. Оба препарата в России не зарегистрированы для лечения ИТП. Это перспектива.
При неуспешности разных вариантов терапии в последующих линиях терапии рекомендуется использование нереализующего метода или проведение комплексной терапии с использованием иммуносупрессоров.
Как правило, современные методы терапии все же позволяют достигнуть ремиссии различной длительности или состояния клинической компенсации. Но четкие прогностические критерии течения заболевания, ответа на терапию и исходов болезни до сих пор не разработаны – из-за природы и непредсказуемого течения заболевания.
Приступая к терапии хронической, рецидивирующей ИТП, необходимо помнить, что выбор терапии должен быть направлен на купирование кровотечения любой локализации, улучшение качества жизни больного, а не на нормализацию количества тромбоцитов любой ценой.
В клинической практике важно помнить, что терапию всегда следует подбирать индивидуально для конкретного пациента с учетом его возраста, коморбидности, сопутствующей патологии, а также учитывать предпочтения больного. Но наша практика часто сталкивается с объективными реалиями жизни.
По данным Е.Ю. Красильниковой (руководителя проектного офиса «Редкие (орфанные) болезни» Национального НИИ общественного здоровья им. Н.А. Семашко), при подготовке Ежегодного бюллетеня по редким (орфанным) заболеваниям9 была получена информация от 76 регионов РФ, в которых на 1 января 2021 года проживало 3 860 пациентов с ИТП (из них 873 – дети), в лекарственной терапии нуждались 2069 человек (из них 468 – дети), получали лекарственную терапию 1 606 пациентов (из них 446 – дети). То есть патогенетическим лечением обеспечено 42% пациентов, внесенных в Федеральный регистр лиц, страдающих редкими жизнеугрожающими заболеваниями.8
Фактически более половины пациентов не получают предназначенное орфанное лечение. Качество оказания медицинской помощи, которое включает диагностику, определение тактики терапии, коррекцию и контроль над этими показателями, стало возможным благодаря разработке схемы маршрутизации пациента, которая представляет путь больного от установления диагноза до обеспечения необходимыми лекарственными препаратами, то есть от лечащего врача до включения пациентов в список федерального регистра.
Наш опыт работы с региональными гематологами показывает, что все они хорошо осведомлены и соблюдают пути маршрутизации пациентов для получения орфанных лекарственных препаратов. В трудных ситуациях они обращаются в федеральные центры для получения решения врачебной комиссии по дорогостоящим препаратам. Обеспечение же в регионах только 42% пациентов с ИТП современными дорогостоящими орфанными ЛС главным образом связано с недостаточным финансированием в ряде регионах. И это тоже имеет свое объяснение. Число пациентов, нуждающихся в дорогостоящих орфанных препаратах, благодаря улучшению их диагностики увеличивается. Единственный выход – включение ИТП в федеральную программу финансирования высокозатратных нозологий.
Таким образом, идиопатическая тромбоцитопеническая пурпура (ИТП) – редкое (орфанное) хроническое, рецидивирующее заболевание, значительно ухудшающее здоровье и качество жизни больных по оценкам физического, социального функционирования, психического состояния. Кровотечения вызывают у них страх, тревожность и депрессию при кратковременном эффекте от проведенной терапии и побочных эффектах лекарств на фоне длительного лечения кортикостероидами, иммуносупрессорами.
ИТП полностью излечить нельзя, но можно эффективно сдерживать. Появившиеся в последние годы современные лекарственные препараты (агонисты тромбопоэтиновых рецепторов) при адекватном выборе дозы и контроля течения заболевания позволяют быстро купировать геморрагический синдром, достигать ремиссии различной длительности или состояния клинической компенсации, предотвращать развитие тяжелых побочных эффектов лечения, улучшать прогноз заболевания, что, естественно, не только повышает продолжительность жизни пациентов с орфанными заболеваниями, но и ее качество. Поэтому очень важно их включение в терапию всех пациентов, нуждающихся в ней. Сегодня эта равная доступность возможна лишь при включении ИТП в федеральную программу финансирования высокозатратных нозологий.
Литература
- «Об основах охраны здоровья граждан в РФ» № 323-ФЗ от 21.11.2011. РГ, федеральный выпуск № 263 (5639) (от 23 ноября 2011 г.). https://rg.ru/2011/11/23/zdorovie-dok.html
- Постановление Правительства РФ № 403 от 26.04.2012 «О порядке ведения Федерального регистра лиц, страдающих жизнеугрожающими и хроническими прогрессирующими редкими (орфанными) заболеваниями, приводящими к сокращению продолжительности жизни граждан или их инвалидности, и его регионального сегмента». 2 мая 2012. https://www.garant.ru/products/ipo/prime/doc/70068888/
- Черников М.В., Куликов С.М., М. А. Русинов М.А. и соавт. Мультинозологический регистр заболеваний системы крови. Состав, структура, итоги опытной эксплуатации // Гематология и трансфузиология. Т. 59, № 1, 2014, с. 30.Меликян А.Л., Егорова Е.К., Пустовая Е.И., Колошейнова Т.И., Володичева Е.М., Капорская Т.С., Ильясов Р.К., Шелехова Т.В., Федорова Н.А., Зотова И.И., Сычева Т.М., Контиевский И.Н., Шестопалова И.А., Куркина Н.В., Сырцева Е.Б., Тарасенко Е.В. Промежуточные результаты эпидемиологического исследования идиопатической тромбоцитопенической пурпуры у взрослых в Российской Федерации // Гематология и трансфузиология. 2021. Т 64. № 4. С. 436‒446.
- Меликян А.Л., Пустовая Е.И., Егорова Е.К., Калинина М.В., Колошейнова Т.И., Суборцева И.Н., Гилязитдинова Е.А., Двирнык В.Н. Дифференциальная диагностика тромбоцитопений // Онкогематология. 2017;12(1):78‒87. https://doi.org/10.17650/1818-8346-2017-12-1-78-87
- Neunert C, Terrell DR, Arnold DM, et al. American Society of Hematology 2021 guidelines for immune thrombocytopenia. 2019;3(23):3829‒3866. doi:10.1182/bloodadvances.201900096
- Меликян А.Л., Пустовая Е.И., Егорова Е.К., Калинина М.В., Колошейнова Т.И., Суборцева И.Н., Гилязитдинова Е.А., Двирнык В.Н. Дифференциальная диагностика тромбоцитопений // Онкогематология. 2017;12(1):78‒87. https://doi.org/10.17650/1818-8346-2017-12-1-78-87
- Provan D, Arnold DM, Bussel JB, et al. Updated international consensus report on the investigation and management of primary immune thrombocytopenia. Blood Adv. 2019;3(22):3780‒3817. doi:10.1182/bloodadvances.2019000812
- Ежегодный бюллетень экспертного совета по редким (орфанным) заболеваниям. https://komitet2-.km.duma.gov.ru/upload/site21/Byulleten_po_redkim_zabolevaniyam_2020.pdf
- Клинические рекомендации «Идиопатическая тромбоцитопеническая пурпура (ИТП) у взрослых» (утв. Минздравом России), 2021. https://npngo.ru/uploads/media_document/283/5eb37419-9276-4e9a-b075-0e26a788f623.pdf
Причины
Почему возникает данная болезнь, неизвестно. Врачи говорят о наследственной предрасположенности и негативном действии следующих факторов:
- бактериальные и вирусные инфекции;
- прививки;
- избыточное облучение солнечной радиацией (инсоляция);
- общее переохлаждение организма;
- некоторые медикаменты («Индометацин», «Фуросемид»).
На поверхности тромбоцитов имеются молекулярные комплексы — антигены. Если в организм попадает чужеродный антиген, иммунная система тут же начинает вырабатывать специфические антитела. Взаимодействуя с антигенами, они разрушают клетки, на поверхности которых находятся.
При эссенциальной тромбоцитопении в селезенке вырабатываются антитела к антигенам своих тромбоцитов. Они фиксируются на тромбоцитных мембранах и как бы помечают их. При прохождении через селезенку форменные элементы крови захватываются и разрушаются.
Из-за уменьшения количества тромбоцитов печень начинает их усиленного вырабатывать. Скорость созревания мегакариоцитов и образования из них тромбоцитов в красном костном мозге значительно увеличивается. Но постепенно компенсаторные возможности костного мозга истончаются, болезнь дает о себе знать.
Если диагностируется аутоиммунная тромбоцитопения при беременности, это значит, что антитела к собственным тромбоцитам проходят через плацентарный барьер и разрушают нормальные тромбоциты плода. В итоге ребенок может родиться больным.
Тромбоцитопения потребления
Тромбоциты активируются в сосудистом русле, запускается механизм свертывания крови. Из-за усиленного потребления тромбоцитов красный костный мозг начинает их активно продуцировать, и если причина патологии вовремя не будет устранена, их уровень в крови уменьшится до критической отметки.
К активации форменных элементов приводят:
- Тромботическая тромбоцитопеническая пурпура. Вызвана недостаточным количеством в крови простациклина. Данный противосвертывающий фактор вырабатывается эндотелием и не дает тромбоцитам склеиваться друг с другом. Когда нарушается его выделение, происходит местная активация тромбоцитов, формируются микротромбы. Сосуды повреждаются, развивается внутрисосудистый гемолиз.
- Синдром диссеминированного внутрисосудистого свертывания. Появляется вследствие сильного повреждения внутренних органов или тканей (инфекции, ожоги, травмы, операции и пр.), из-за чего свертывающая система крови истощается. В сосудистом русле образуются многочисленные тромбы. Они закупоривают мелкие сосуды, препятствуют нормальному кровоснабжению почек, мозга и других органов. В ответ активируется противосвертывающая система, нацеленная на восстановление кровотока путем разрушения тромбов. Со временем кровь полностью утрачивает способность сворачиваться. Могут возникнуть сильные внутренние кровотечения, которые приводят к летальному исходу.
- Гемолитико-уремический синдром. Связан с кишечными инфекциями, наследственной предрасположенностью, системными заболеваниями и приемом некоторых медикаментов. В кровь выделяются бактериальные токсины. Они повреждают эндотелий сосудов, активируют тромбоциты путем присоединения их к поврежденным участкам. В результате образуются микротромбы, микроциркуляция внутренних органов нарушается.
Тромбоцитопения перераспределения
В норме в селезенке откладывается около 30% всех тромбоцитов. При некоторых заболеваниях орган сильно увеличивается в размерах, из-за чего в нем депонируется до 90% форменных элементов крови. Заболевание может быть вызвано циррозом печени, красной системной волчанкой, инфекциями, опухолями, алкоголизмом.
Тромбоцитопения разведения
Развивается у больных, которым переливают большие объемы плазмы, жидкостей, эритроцитарной массы, плазмозаменителей, не возмещая при этом тромбоциты. В итоге концентрация последних снижается до такого уровня, что даже их выброс из депо не способен поддержать нормальную работу свертывающей системы.
Этиология и патогенез
При тромбоцитопенической пурпуре тромбоцитопения развивается вследствие разрушения тромбоцитов посредством иммунных механизмов. Антитела к собственным тромбоцитам могут появляться спустя 1-3 нед после перенесённых вирусных или бактериальных инфекций, профилактических прививок, приёма лекарственных препаратов при индивидуальной их непереносимости, переохлаждения или инсоляции, после хирургических операций, травм. В ряде случаев какую-либо определённую причину выявить не удаётся. Поступившие в организм антигены (например, вирусы, лекарственные средства, в том числе вакцины) оседают на тромбоцитах больного и индуцируют иммунный ответ. Антитромбоцитарные антитела относят преимущественно к IgG. Реакция «Аг-AT» происходит на поверхности тромбоцитов. Продолжительность жизни тромбоцитов, нагруженных антителами, при тромбоцитопенической пурпуре снижена до нескольких часов вместо 7-10 дней в норме. Преждевременная гибель тромбоцитов происходит в селезёнке. Кровоточивость при тромбоцитопенической пурпуре обусловлена снижением количества тромбоцитов, вторичным повреждением сосудистой стенки в связи с выпадением ангиотрофической функции тромбоцитов, нарушением сократительной способности сосудов из-за понижения концентрации серотонина в крови, невозможностью ретракции кровяного сгустка.
Симптомы тромбоцитопении
Механизм развития симптомов тромбоцитопении всегда одинаков. Из-за снижения концентрации тромбоцитов нарушается питание стенок кровеносных сосудов, увеличивается ломкость капилляров. В определенный момент по причине незначительного физического фактора или спонтанно целостность капилляров нарушается, возникает сильное кровотечение (его обычно изображают на фото тромбоципении). Нехватка тромбоцитов не дает образоваться тромбоцитарной пробке в лопнувших сосудах, поэтому кровь из циркуляционного русла изливается в окружающие ткани.
Основные симптомы тромбоцитопении:
- Пурпура (кровоизлияние в слизистые, кожу). На теле образуются мелкие красные пятнышки. Они не исчезают при надавливании, не болят и не возвышаются над поверхностью кожи. Их размер может составлять от нескольких миллиметров до нескольких сантиметров в диаметре. Параллельно могут появляться синяки.
- Кровоточивость десен. Образуется на большой поверхности и долго не прекращается.
- Частые кровотечения из носа. Могут быть вызваны чиханием, микротравмами, простудными заболеваниями. Выходящая кровь имеет ярко-красный цвет. Иногда кровотечение не удается остановить целый час.
- Гематурия (кровь в моче). Возникает из-за кровоизлияния в слизистые мочевого пузыря либо мочевыводящих путей.
- Желудочные и кишечные кровотечения. Являются следствием повышенной ломкости сосудов слизистой ЖКТ, травмирования его грубой пищей. Кал приобретает красный цвет, может быть рвота кровавыми массами.
- Обильные и длительные менструальные кровотечения.
Если Вы обнаружили у себя схожие симптомы, незамедлительно
обратитесь к врачу. Легче предупредить болезнь, чем бороться с последствиями.
Клиническая картина болезни Верльгофа
Заболевание начинается исподволь или остро с появления геморрагического синдрома. Тип кровоточивости при тромбоцитопенической пурпуре петехиально-пятнистый (синячковый). По клиническим проявлениям выделяют два варианта тромбоцитопенической пурпуры: «сухой» — у больного возникает только кожный геморрагический синдром; «влажный» — кровоизлияния в сочетании с кровотечениями. Патогномоничные симптомы тромбоцитопенической пурпуры — кровоизлияния в кожу, слизистые оболочки и кровотечения. Отсутствие этих признаков вызывает сомнение в правильности диагноза.
- Кожный геморрагический синдром возникает у 100% больных. Количество экхимозов варьирует от единичных до множественных. Основные характеристики кожного геморрагического синдрома при тромбоцитопенической пурпуре следующие.
Несоответствие выраженности геморрагии степени травматического воздействия; возможно их спонтанное появление (преимущественно ночью). - Полиморфизм геморрагических высыпаний (от петехий до крупных кровоизлияний).
- Полихромность кожных геморрагии (окраска от багровой до сине-зеленоватой и жёлтой в зависимости от давности их появления), что связано с постепенным превращением гемоглобина через промежуточные стадии распада в билирубин.
- Асимметрия (нет излюбленной локализации) геморрагических элементов.
- Безболезненность.
Характерные изменения внутренних органов при тромбоцитопенической пурпуре отсутствуют. Температура тела обычно нормальная. Иногда выявляют тахикардию, при аускультации сердца — систолический шум на верхушке и в точке Боткина, ослабление I тона, обусловленные анемией. Увеличение селезёнки нехарактерно и скорее исключает диагноз тромбоцитопенической пурпуры.
По течению выделяют острые (длительностью до 6 мес) и хронические (продолжительностью более 6 мес) формы заболевания. При первичном осмотре установить характер течения заболевания невозможно. В зависимости от степени проявления геморрагического синдрома, показателей крови в течении заболевания выделяют три периода: геморрагический криз, клиническая ремиссия и клинико-гематологическая ремиссия.
- Геморрагический криз характеризуется выраженным синдромом кровоточивости, значительными изменениями лабораторных показателей.
- Во время клинической ремиссии исчезает геморрагический синдром, сокращается время кровотечения, уменьшаются вторичные изменения в свёртывающей системе крови, но тромбоцитопения сохраняется, хотя она менее выраженная, чем при геморрагическом кризе.
- Клинико-гематологическая ремиссия подразумевает не только отсутствие кровоточивости, но и нормализацию лабораторных показателей.
Диагностика
О наличии тромбоцитопении у детей и взрослых говорит уменьшение количества тромбоцитов в крови. Чтобы поставить точный диагноз и назначить качественное лечение проводятся дополнительные исследования, которые можно пройти в любой современной клинике гематологии
:
- общий анализ крови;
- оценка продолжительности времени кровотечения по Дьюку;
- пункция красного костного мозга (позволяет изучить состояние системы кроветворения);
- определение времени свертывания крови;
- генетическое исследование (осуществляется, если подозревается наследственная тромбоцитопения);
- определение антител в крови (уточнение соотношения антител и тромбоцитов);
- УЗИ (дает возможность изучить плотность и структуру внутренних органов, определить размеры печени, селезенки);
- МРТ (для получения послойного изображения сосудов и внутренних органов).
Для чего нужны тромбоциты?
Тромбоциты (кровяные пластинки) — один из трех видов форменных элементов крови (два других вида — лейкоциты и эритроциты). Их часто называют клетками крови, но на самом деле они не являются таковыми, а представляют собой отшнуровавшиеся фрагменты мегакариоцитов — особой разновидности гигантских клеток, которые находятся в красном костном мозге.
Некоторые факты о тромбоцитах:
- Два основных свойства кровяных пластинок — способность к прилипанию и склеиванию. За счет этого тромбоциты формируют пробку, которая перекрывает просвет сосуда при его повреждении.
- Кроме того, тромбоциты выделяют активные вещества, которые принимают участие в процессе свертывания крови и последующем разрушении тромба.
- Нормальные размеры кровяных пластинок — 1–4 микрометра.
- В среднем тромбоцит живет 8 суток.
Нормальное содержание тромбоцитов в крови — 150–300*109 на литр. Тромбоцитопенией называют состояние, при котором этот показатель меньше.
Лечение тромбоцитопении
Лечением тромбоцитопении занимается гематолог. Сначала оценивается состояние пациента, изучается, насколько выражен геморрагический синдром.
- При легкой степени тяжести (50 000-150 000 тромбоцитов в мкл крови) стенки капилляров находятся в нормальном состоянии, поэтому кровь не выходит из сосудистого русла. Сильные кровотечения не развиваются. Следовательно, решить проблему можно без лекарственных средств. Осуществляется выяснение причины заболевания. Врач придерживается выжидательной тактики. Госпитализация больного не производится.
- При средней степени тяжести (25 000-50 000 тромбоцитов в мкл крови) наблюдаются кровоизлияния в слизистую ротовой полости, носовые кровотечения. При незначительных ушибах образуются большие кровоподтеки. Если есть риск развития кровотечений (наличие язвы желудка, занятие профессиональным спортом и др.), проводится медикаментозная терапия. Больной может проходить лечение в домашних условиях.
- При тяжелой степени тяжести тромбоципении (менее 20 000 тромбоцитов в мкл крови) возникают спонтанные кровотечения в слизистые рта, кожу. Проявляется геморрагический синдром. Обязательно назначение комплексной медикаментозной терапии. Пациента госпитализируют.
Лечение тромбоцитопении с помощью лекарственных средств
Медикаментозное лечение при любой форме тромбоцитопении направлено на:
- прекращение кровотечений;
- устранение причины;
- лечение болезни, вызвавшей проблему.
Обычно больным назначаются препараты:
- «Преднизолон»;
- «Интраглобулин», «Имбиогам»;
- «Револейд»;
- «Винкристин»;
- «Этамзилат»;
- «Депо-провера»;
- витамин В12.
Немедикаментозные методы лечения тромбоцитопении
Лечение тромбоципении может осуществляться с помощью терапевтических и хирургическим мероприятий. Наиболее часто гематологи прибегают к:
- Трансфузионной терапии. Больному переливают донорскую кровь (плазму или тромбоциты).
- Удалению селезенки. Селезенка — основной источник антител при иммунной тромбоцитопении и основное место разрушения тромбоцитов, поэтому иногда прибегают к ее полному либо частичному удалению. У большинства пациентов после удаления селезенки при тромбоцитопении состояние нормализуется, исчезают клинические симптомы заболевания.
- Пересадке костного мозга. Сначала пациенту назначают большие дозы противоопухолевых лекарственных препаратов, которые угнетают иммунную систему. Это делается для того, чтобы предотвратить реакцию иммунитета на введение костного мозга донора, а также разрушить опухолевые клетки, если речь об опухоли системы кроветворения.
Лечение тромбоцитопении при беременности
Тромбоцитопения у беременных требует грамотного лечения. Обычно будущим мамам назначают короткие курсы глюкокортикостероидов («Дексаметазон», «Преднизолон»). В третьем триместре они ускоряют созревание легких плода, что делает возможным досрочное родоразрешение.
Если глюкокортикостероиды оказываются неэффективными, внутривенно вводится иммуноглобулин. За всю беременность его используют три-четыре раза, после еще раз сразу после родов. В неотложных ситуациях прибегают к переливанию тромбоцитарной массы.
Если все принятые меры не позволяют устранить симптомы заболевания, во втором триместре селезенку удаляют (особенно часто к операции прибегают, если диагностирована тяжелая степень гестационной тромбоцитопении в первом триместре). В идеале хирургическое вмешательство должно быть проведено лапароскопическим доступом.
Вопрос о родоразрешении всегда решается в индивидуальном порядке. Тромбоцитопения в родах может привести к сильному кровотечению, поэтому врачи тщательно взвешивают все «за» и «против». Менее травматичной для женского организма считается операция кесарева сечения.
Лечение тромбоцитопении народными средствами
Лечение тромбоцитопении проводится с помощью листьев крапивы, тысячелистника, земляники. Травы заваривают кипятком и пьют в охлажденном виде по 1/4 стакана 3-4 раза в день.
Хорошо зарекомендовало себя кунжутное масло при тромбоцитопении. Его следует принимать по столовой ложке 3 раза в день.
Как выявляют тромбоцитопению?
Для определения количества тромбоцитов назначают общий анализ крови. В зависимости от степени снижения содержания кровяных пластинок, врач может установить степень тяжести тромбоцитопении:
- умеренная тромбоцитопения — 100–180*109 на литр;
- резкая тромбоцитопения — 60–80*109 на литр;
- выраженная тромбоцитопения — 20–30*109 на литр.
Существует много причин тромбоцитопении. Их можно разделить на две большие группы: врожденные и приобретенные. Врожденные тромбоцитопении возникают в результате наследственных заболеваний, сопровождающихся нарушением кроветворения. При этом нередко изменяется не только количество, но и строение, функции кровяных пластинок.
Причины приобретенной тромбоцитопении: разведение крови (переливание растворов после большой кровопотери), скопление тромбоцитов в одном месте (например, в увеличенной селезенке), повышенное потребление кровяных пластинок при свертывании крови, разрушение в результате действия токсинов, иммунных реакций и воздействия других факторов.
Тромбоцитопения может быть самостоятельным заболеванием — это идиопатическая тромбоцитопеническая пурпура, или болезнь Верльгофа, состояние, при котором организм вырабатывает антитела против собственных тромбоцитов. В остальных случаях тромбоцитопения является лишь одним из симптомов какого-либо другого заболевания.
Причины умеренной тромбоцитопении
- Систематическое злоупотребление алкоголем, алкоголизм. Алкоголь подавляет работу красного костного мозга и вызывает дефицит фолиевой кислоты, которая нужна для кроветворения.
- Беременность. Во время беременности в организме женщины возникает много причин для развития тромбоцитопении (гормональная перестройка, разжижение крови, повышенная потребность в витаминах, аллергические реакции и пр.).
- Заболевания печени. В печени синтезируются некоторые вещества, принимающие участие в свертывании крови. Когда их выработка уменьшается, развивается повышенная кровоточивость, организм потребляет повышенное количество тромбоцитов. Кроме того, кровяные пластинки скапливаются в увеличенной селезенке.
- Применение некоторых лекарств. К тромбоцитопении могут приводить мочегонные препараты, нитроглицерин, анальгин, гепарин, витамин K, резерпин, антибиотики, цитостатики (противоопухолевые препараты).
- ДВС-синдром (диссеминированное внутрисосудистое свертывание). Это состояние, при котором в мелких сосудах происходит свертывание крови и образование большого количества микротромбов — идет интенсивное расходование тромбоцитов и снижение их уровня в крови. ДВС-синдром может развиваться при различных патологиях, например, при инфекциях и интенсивных кровотечениях.
- Системная красная волчанка и системные васкулиты. Тромбоцитопения возникает в результате аутоиммунного процесса.
- Сердечная недостаточность. Состояние, при котором сердце не может полноценно обеспечить кровоснабжение органов. Иногда при этом кровь застаивается в селезенке — она увеличивается, и в ней скапливаются тромбоциты. Также тромбоциты расходуются в результате роста тромбов в сосудах, где происходит застой крови (в частности, в венах нижних конечностей).
- Лучевая терапия. Излучение, которое уничтожает опухолевые клетки, одновременно может повредить ткань красного костного мозга, в результате чего нарушается образование эритроцитов, лейкоцитов, тромбоцитов.
Причины резкой тромбоцитопении:
- Системная красная волчанка.
- Тяжелый ДВС-синдром.
- Острые лейкозы. При лейкозах в красном костном мозге возникают злокачественные клетки, которые постепенно размножаются и вытесняют нормальную кроветворную ткань. В итоге нарушается образование эритроцитов и тромбоцитов.
- Гемолитическая болезнь новорожденного. Развивается при несовместимости крови матери и плода (по группе крови AB0, резус-фактору). В организме матери вырабатываются антитела против крови ребенка.
Причины выраженной тромбоцитопении:
- Острая лучевая болезнь. В том числе может развиваться после чрезмерных доз лучевой терапии.
- Передозировка цитостатиков. Эти препараты применяются для лечения злокачественных опухолей и некоторых других заболеваний.
- Тяжелое течение острого лейкоза.
Симптомы тромбоцитопении зависят от основного заболевания. Общие признаки:
- беспричинное появление синяков на коже;
- медленная остановка кровотечения после порезов;
- частые носовые кровотечения;
- повышенная кровоточивость слизистой оболочки рта — в слюне появляются примеси крови;
- люди с тромбоцитопенией имеют повышенный риск кровотечений во внутренних органах, кровоизлияний в головной мозг.
При появлении этих симптомов нужно посетить врача и сдать общий анализ крови. Если в нем будут обнаружены изменения, то терапевт направит вас к гематологу для дальнейшего обследования. Умеренную и резкую тромбоцитопению зачастую можно лечить амбулаторно. Выраженная тромбоцитопения — опасное состояние, при котором больного немедленно помещают в палату интенсивной терапии. Тактика лечения определяется основным заболеванием, которое привело к снижению количества тромбоцитов.
Запись на консультацию круглосуточно
+7+7+78